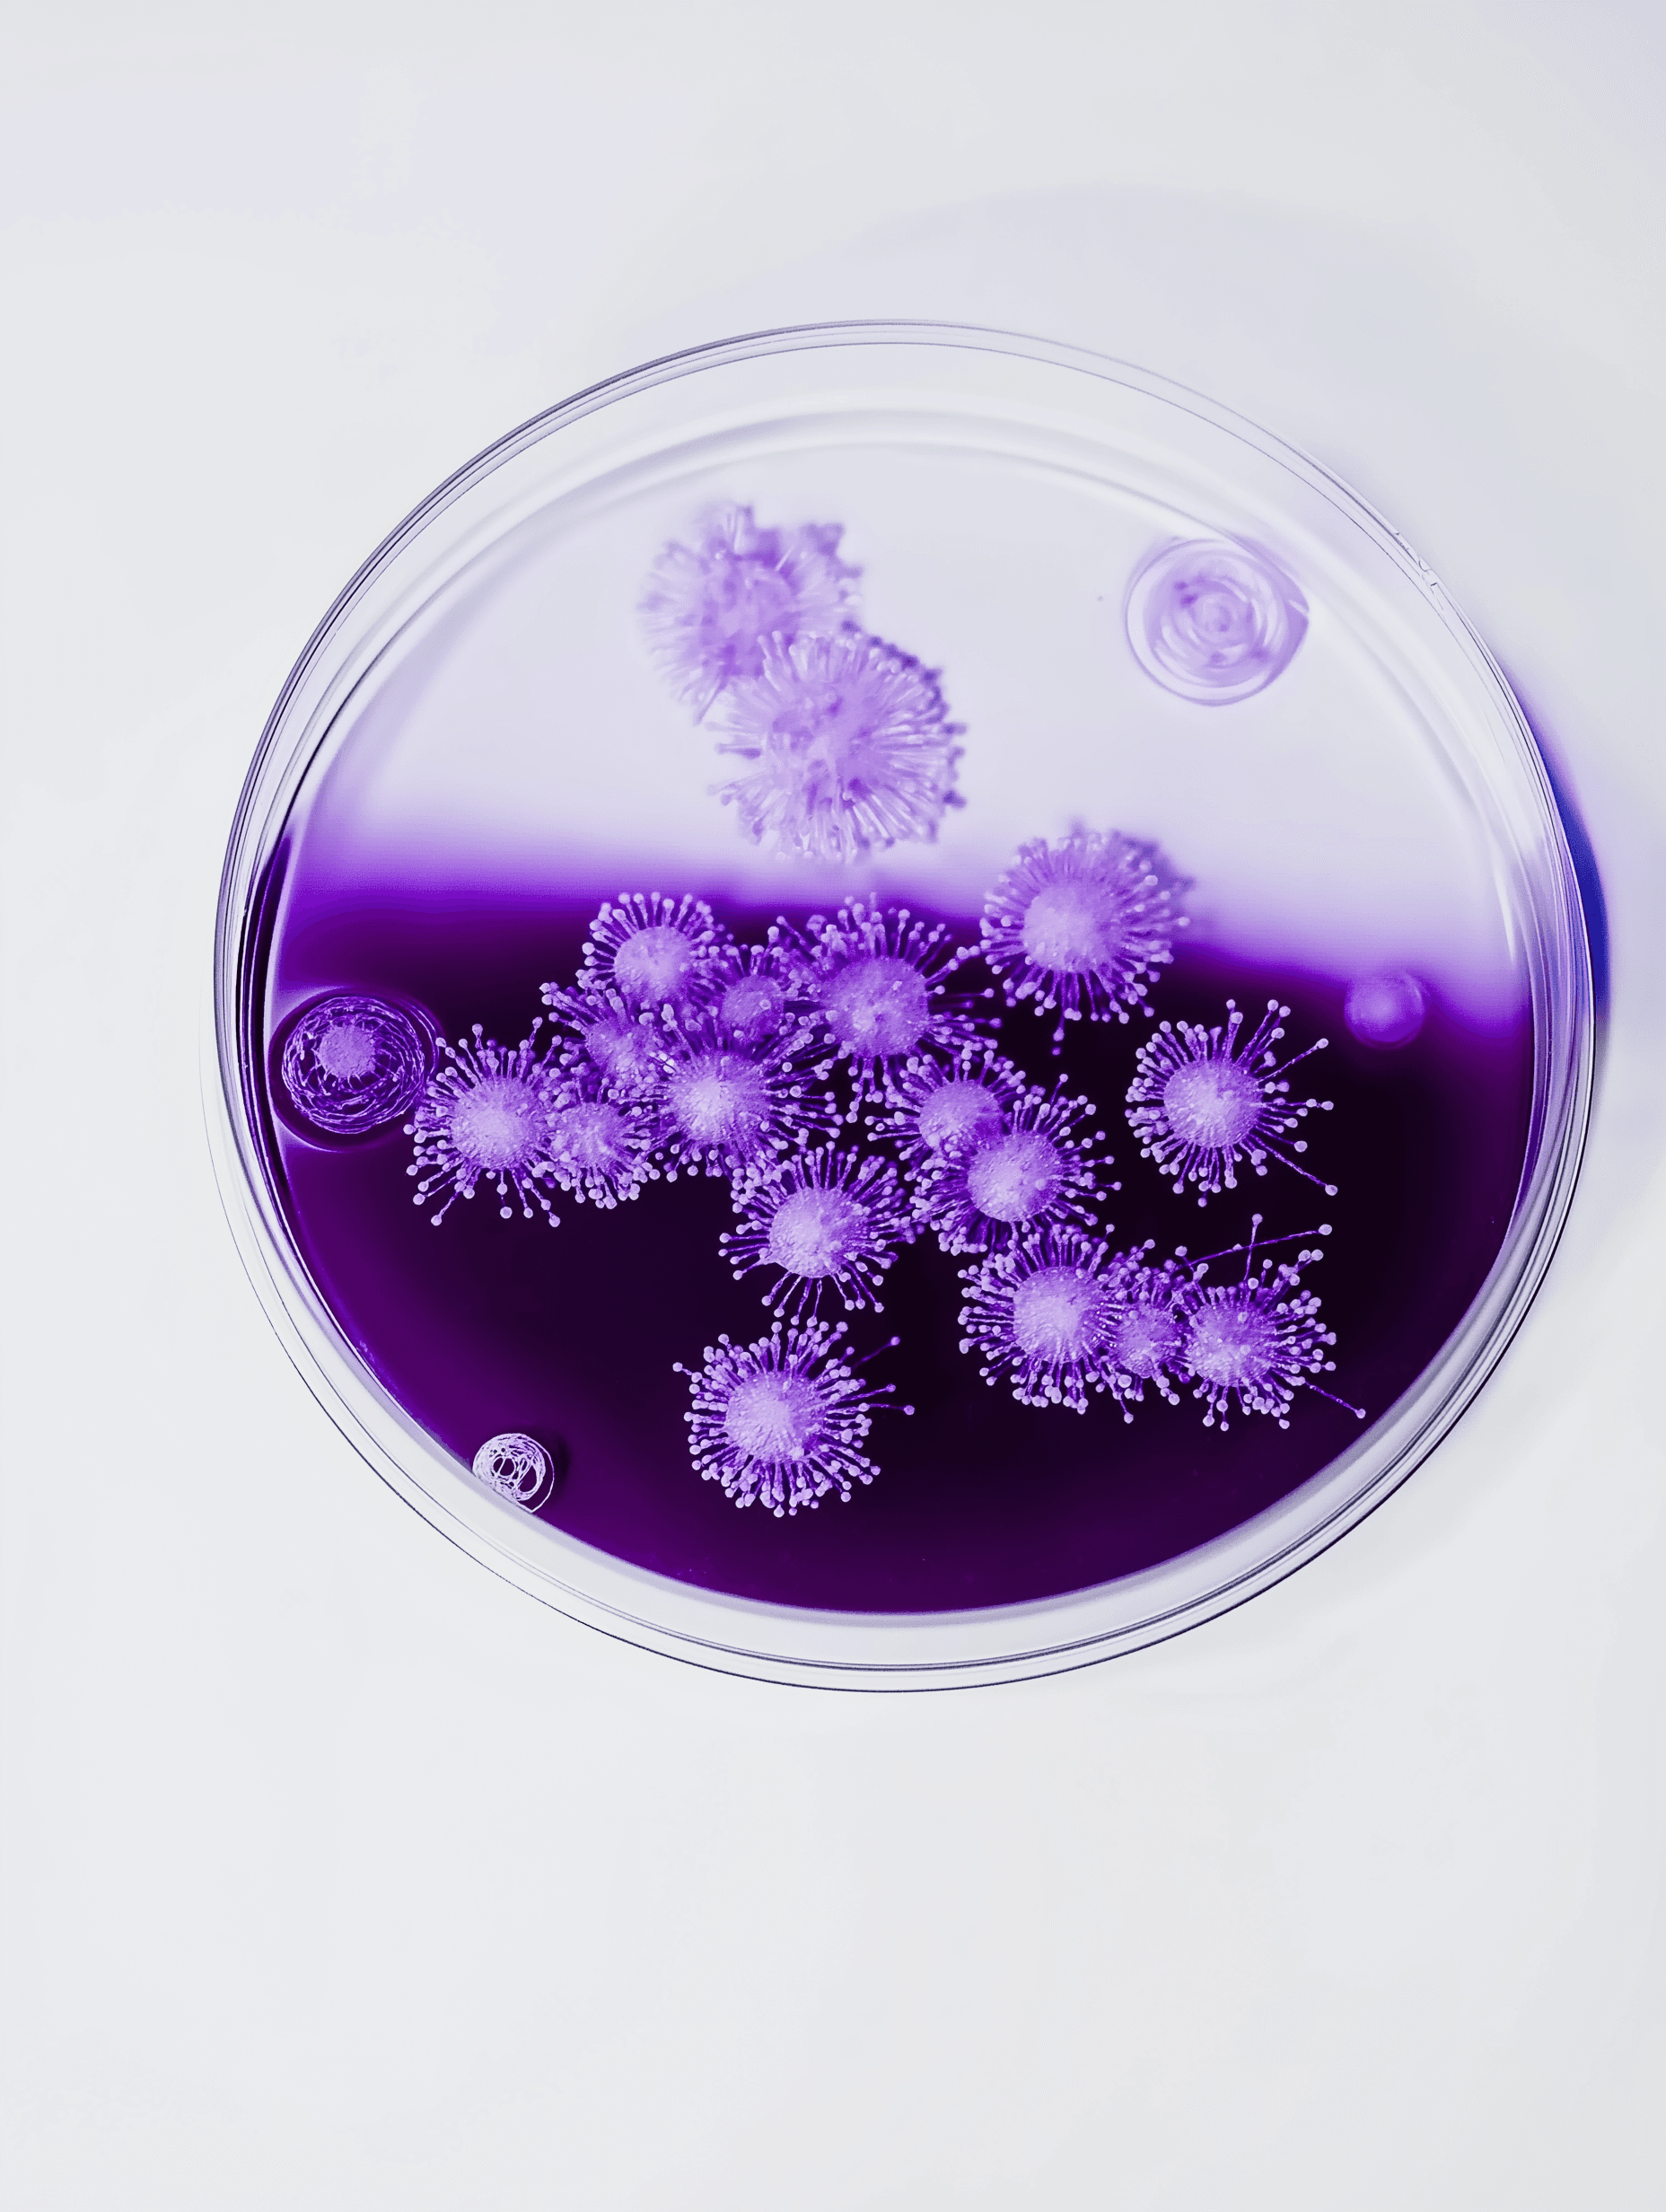

MonitorizareEpidemiologică
Platforma completă pentru monitorizarea epidemiologică spitalicească și formarea personalului medical.
Modul Raportare
Observare directă & Igiena mâinilor
Autocontrol Bacteriologic
Gestionare probe bacteriologice
Autocontrol ATP & Fluorescență
Monitorizare igienă
Modul Testare
Cursuri și evaluări personal medical
Funcționalități Esențiale
Monitorizare EpidemiologicăCompletă & Integrată
Platforma oferă toate instrumentele necesare pentru monitorizarea epidemiologică spitalicească, de la rapoarte de observație directă la formarea specialistă a personalului medical.
Monitorizare
Rapoarte Observație Directă
Sisteme complete pentru crearea și gestionarea rapoartelor de observație directă și monitorizare epidemiologică în timp real.
Observație în timp real
Rapoarte automate
Analiza datelor
Igienă
Monitorizare Igiena Mâinilor
Instrumente specializate pentru monitorizarea și raportarea conformității cu practicile de igienă a mâinilor în mediul spitalicesc.
Urmărire conformitate
Rapoarte detaliate
Indicatori performanță
Formare
Formare & Verificare Personal
Platformă completă pentru formarea personalului medical din perspectivă epidemiologică și verificarea competențelor dobândite.
Module interactive
Teste de competență
Certificări personalizate
Laborator
Autocontrol
Sistem avansat pentru crearea și gestionarea rapoartelor de autocontrol bacteriologic, ATP și Fluorescență și managementul probelor colectate.
Gestionare probe
Rezultate în timp real
Analiza tendințelor
Competențe
Verificare Competențe
Sistem complet pentru evaluarea și certificarea competențelor epidemiologice ale personalului medical cu urmărire continuă.
Teste standardizate
Evaluare continuă
Rapoarte progres
Date
Gestionare Centralizată Date
Platformă securizată pentru stocarea și gestionarea tuturor datelor epidemiologice, probelor și rapoartelor într-un sistem integrat.
Stocare securizată
Acces controlat
Export standardizat